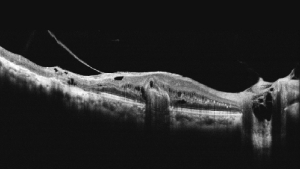
MOCEAN 4000 SLO OCT
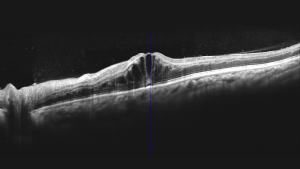
A premium OCT for advanced practice

Оптично Когерентний Томограф Mocean 4000 Moptim

Оптично Когерентний Томограф Mocean 4000 – безконтактний прилад для томографічних та біомікроскопічних зображень з високою роздільною здатністю. Використовується для отримання зображень в реальному часі, осьового поздовжнього перетину та тривимірного зображення, обстеження передньої та задньої окулярних структур, включаючи рогівку, сітківку, шар нервових волокон сітківки, макулярну область та диск зорового нерву.
Основні характеристики
- Висока швидкість сканування: 130 000 A-сканів/с або 80 000 A-сканів/с.
- Усереднення до 100 зображень підвищує якість ОКТ зображення.
- Глибина сканування 3 мм забезпечує кращу деталізацію склоподібного тіла, сітківки та судинної оболонки
- Відстеження сітківки на основі SLO
- Кутове сканування 16 мм.
- Комплексний аналіз сітківки, глаукоми та рогівки
- Оновлення до аналізу VASCAN OCTA (опціонально)
Особливості
Чудова якість ОКТ-зображень з усередненням 100 зображень
Mocean 4000 робить 100 зображень менш ніж за одну секунду і об'єднує їх разом для створення зображення високої чіткості з мінімізованим шумом зернистості
Осьова оптична роздільна здатність 5 мкм (цифрова - 3 мкм)
ОКТ-зображення з високою роздільною здатністю виявляє приховані патологічні зміни

Висока якість SLO в режимі реального часу + відстеження руху очей
Ключовою перевагою системи Mocean® 4000 є одночасне отримання поздовжнього ОКТ-зображення та зображення очного дна під кутом 47° за допомогою скануючого лазерного офтальмоскопа (SLO). Це дає вам огляд сітківки, щоб ви могли легко визначити місце ураження ще до отримання зображення. Більш того, система робить до 50 SLO-зображень очного дна протягом однієї секунди, щоб сформувати зображення очного дна у форматі HD.
Висока швидкість сканування 80 000 А-сканів/с
80 000 А-сканів/с дозволяє проводити дослідження за 1,5 секунди при скануванні з високою роздільною здатністю і за 1 секунду при 3D-скануванні.

Кутовий аналіз 16 мм
Сканування від кута до кута 16 мм переднього відрізка з аналізом даних.

Мапа товщини епітелію
Забезпечує відображення товщини епітелію рогівки діаметром 6 мм на карті, що є важливою частиною діагностики в рефракційній хірургії та має багато важливих клінічних застосувань.

Комплексний аналіз глаукоми (ONH/GCC)
Для комплексного аналізу глаукоми Mocean 4000 пропонує дві схеми сканування: сканування куба глаукоми в макулярній області для аналізу комплексу гангліозних клітин та сканування куба глаукоми в ділянці диска для аналізу голівки зорового нерва. Рівномірно розподілені точки відбору зразків зі скануванням 200 x 200 А забезпечують надійну інформацію для раннього виявлення та лікування глаукоми.

Режим глибокої судинної томографії (DCI)
Використання глибокої судинної томографії для виявлення неоваскуляризації судинної оболонки.

Комплексний аналіз програмного забезпечення та безкоштовне оновлення
Система Mocean® 4000 пропонує 8 моделей сканування, які допоможуть вам підвищити ефективність діагностики:
Макулярна область (HD однолінійне, шестилінійне та перехресне сканування, сканування макулярного кубу)
Глаукома (Сканування кубу диску для аналізу ONH, сканування макулярного кубу для аналізу GCC)
Передній сегмент (HD однолінійне та шестилінійне сканування, сканування від кута до кута)

Додатковий модуль VASCAN™ OCTA
*Модуль ангіографії VASCAN™ OCT - це додатковий програмний модуль для Mocean 4000.
Ангіографія оптичної когерентної томографії (OCTA) - це новий неінвазивний метод візуалізації, який дозволяє детально аналізувати потік у судинній структурі ока без застосування барвників.
- Надчітке ангіографічне зображення на основі алгоритму COMAG з використанням фазових та амплітудних сигналів;
- Широкопольна OCTA-зображення до 12 мм x 8 мм.
Технічні характеристики
ОКТ Зображення | |
| Метод | Спектральна інтерферометрія |
| Оптичне джерело | Супер люмінесцентний діод 840 нм |
| Швидкість сканування | 80000 А-сканів на секунду |
| Осьова здатність | 5мкн (оптичне), 2,7 мкн ( цифрове) |
| Поперечна здатність | 15мкм (оптичне), 3 мкм (цифрове) |
| Глибина А-сканування | 2,3 мм |
| Діапазон діоптрій | -20 до +20 D |
| Шаблони сканування | Макулярна область: HD лінійне сканування (6 мм або 12 мм), 3D. Диск: 3D cканування (6 мм на 6 мм). Передній сегмент: HD лінійне сканування (6 мм), 6-ти лінійне сканування. |
| Об'єм зображення ангіографії | 256*256 А-сканів |
| Розмір зображення ангіографії | 3*3мм, 6*6 мм, 8*8мм |
Зображення дна ока | |
| Метод | Лінійна скануюча лазерна офтальмоскопія (LSLO) |
| Мінімальний діаметр зіниці | 3,0 мм |
| Поле зору | 45 ± 1° |
VASCAN™ OCTA MODULE (основний / опціональний) | |
| Обсяг/зона сканування | 3 мм x 3 мм 256 x 256 A-сканів |
| 6 мм x 6 мм 512 x 512 A-сканів | |
| 8 мм x 8 мм 512 x 512 A-сканів | |
| 12 мм x 8 мм 540 x 360 A-сканів | |
| Алгоритм | C-OMAG |
| Параметри сегментації | Закодований, Вітреоретинальний інтерфейс (VRI), поверхня сітківки, глибока сітківка, судинний, хоріокапілярний, хоріоїд, індивідуальний |
| Кількісний аналіз | Так |
Пристрій | |
| Частота | 50 Гц-60 Гц |
| Потужність | 90 VA |
| Напруга джерела | ~100-240 В |
| Зовнішні розміри | 532мм(Ш) х 360 мм(Г) х 540 мм(В) |
| Вага | 30,5 кг |










